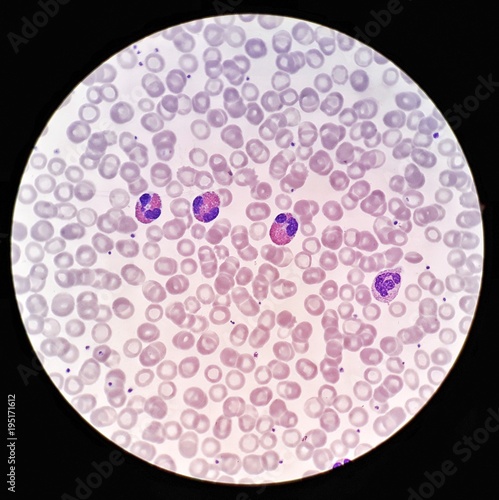
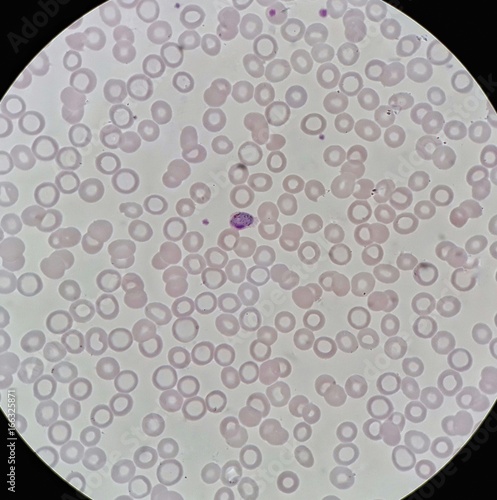
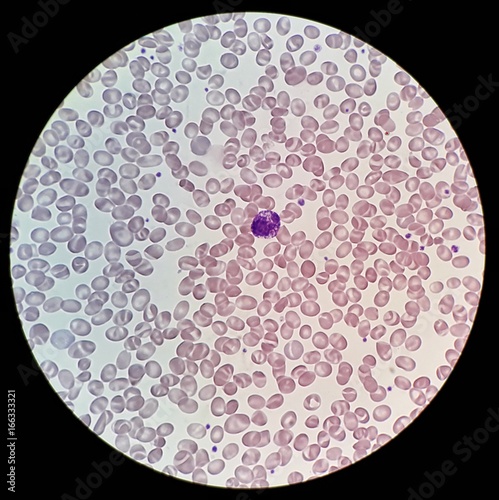

Home ⇨ Blood cells under microscope 100x
Blood Cells Under Microscope 100x
Get Blood cells under microscope 100x For Android - You stare at your desktop wallpaper all day, so why leave it boring or as the Windows 10 default wallpaper? These websites and apps will help. Today i will share Blood cells under microscope 100x wallpaper. Painting Supplies, Tools & Wall Treatments from a great selection at Home Improvement Store.
Get Blood cells under microscope 100x HD